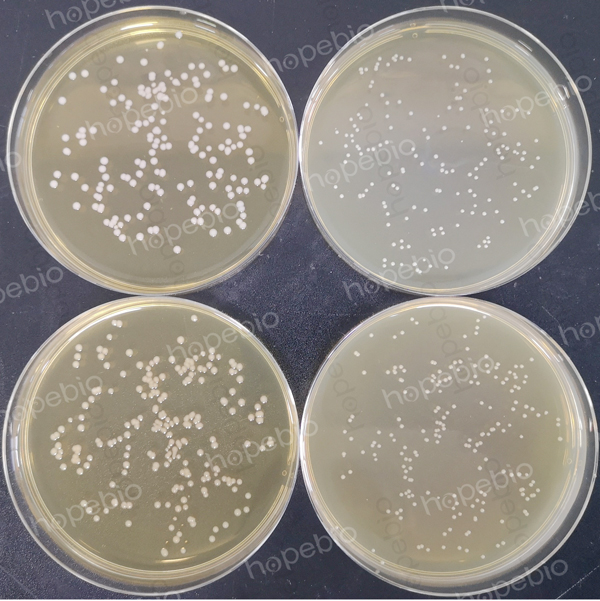
左侧平板含琼脂0.9%，右侧平板含琼脂3%，测试菌株为金黄色葡萄球菌

海博微信公众号
海博微信公众号
 海博天猫旗舰店
海博天猫旗舰店


 海博微信公众号
海博微信公众号
 海博天猫旗舰店
海博天猫旗舰店




一、琼脂的作用
琼脂是由植物中提取的一种多糖,在冷水中不溶解,加热至90℃左右开始溶解,溶解后的琼脂在冷却至40℃左右时开始凝固,性状稳定,在培养基中做为优良的凝固剂使用。
由于生产琼脂的工艺、原材料等因素的影响,不同的琼脂在外观、颜色、软硬度上有差别,特别是软硬度对培养基的影响至关重要。
二、琼脂的软硬度对不同培养基的影响
在一些标准中规定的培养基配方中,通常写明了培养基中使用的琼脂具体用量,也有些配方写的琼脂用量是一个范围。


虽然琼脂在培养基中不提供营养,一般也不能被微生物利用,但琼脂的软硬度会对微生物的生长以及某些扩散性试验(如药敏试验、抗生素效价测定等)的效果产生间接的影响。因此在GB4789.28中规定,允许根据琼脂的实际软硬度调整使用量,在配制培养基时,并不一定要完全按照标准中的配方进行配制,应当根据琼脂的软硬度选择合适的用量。

在观察动力的半固体培养基中,琼脂的用量通常为0.4%左右,一些有动力的细菌可以在半固体琼脂中游动扩散生长,若培养基硬度偏大,会导致细菌难以扩散生长,观察不到动力试验结果。因此,若琼脂的凝胶强度偏大,应适当降低用量,使培养基的软硬度在合适的范围内,可以较好的观察细菌的动力现象。
在平板培养基中,培养基的软硬度与细菌的菌落大小、迁移现象有关。若培养基软硬度较小,培养基内的营养物质容易扩散,有动力的细菌更容易向周围扩散,这样的培养基上细菌的菌落直径会更大一些。若培养基的软硬度较大,细菌的菌落通常会偏小一点。在进行同种培养基比对时,看到菌落大小不同,许多人会误认为菌落较大是因为培养基的营养高,质量好,这种观点是片面的。虽然培养基软硬度较低时菌落更容易长大,但缺点是新手划线接种容易划破,不好操作。对于计数类培养基(如TSA、营养琼脂等),若培养基软硬度偏低,很容易在进行计数培养时由于菌落生长过大出现蔓延或融合遮盖现象,导致计数结果不准确,反而培养基稍硬一些,菌落略微偏小不容易融合蔓延,更容易计数。因此,在进行配制培养基时,应将软硬度控制在一定范围内,一般琼脂的用量在10-15g之间即可。
注:左侧平板含琼脂0.9%,右侧平板含琼脂3%,测试菌株为金黄色葡萄球菌。
注:本文属海博生物原创,未经允许不得转载。
上一篇:常用金黄色葡萄球菌分离培养基比较
下一篇:即用型平板出水情况探究
| 相关文章: | ||



